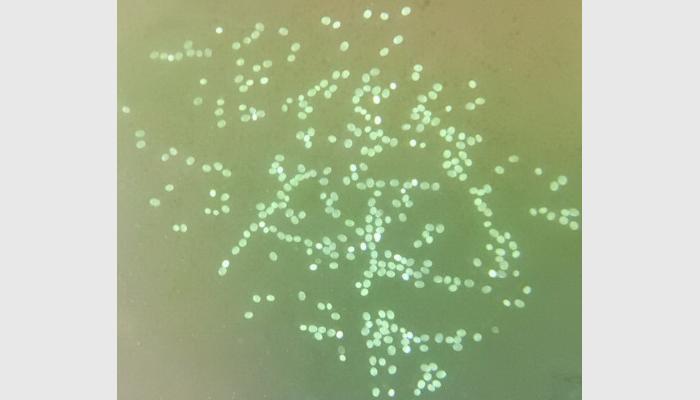

一、用途
自動計數分散狀態的各類魚卵、貝苗種、卵無節幼體、鹵蟲、輪蟲、海參苗,以及類似的其它淡水或海水產幼體,有效減少飼料浪費和勞力成本,提高養殖戶利潤。
二.主要性能指標:
1、由≥11.6寸的自動對焦500萬像素平板電腦拍照,點一下計數按鈕便能自動計數出全部數量。
2、★自動計數目標的大小:1~10mm。適用于自動計數分散狀態的各類魚卵、貝苗種、卵無節幼體、鹵蟲、輪蟲、海參苗,以及其它類似的、不重疊的淡水或海水產幼體。
3、★自動計數速度:2000~30000粒/分鐘(每盤的數粒范圍:200~5000粒),自動計數誤差≤±3 %,極少量監視點選后100%正確。
4、★帶有LED背光的成像增強裝置,使計數目標的識別更穩定,對被點數目標安全、無毒。
5、可存儲上萬張圖片及其對應的數據,可查看結果表、導出至EXCEL,以及無線上網來遠程發送圖片、結果數據。
三、標準配置
1、SC-B2多功能魚卵貝苗自動計數儀系統軟件U盤及軟件鎖1套
2、≥11.6寸/4G以上內存/64G固態硬盤的500萬像素品牌平板電腦 1臺
3、帶有LED背光成像增強裝置1個
4、透明成像盤1個
5、拍照支架1付
備注:
本技術標書中打★款項必須響應,否則為重大偏離。
搜索
產品類別
相關產品
- 萬深LC-D型線束顏色順序檢測儀 >
- LC-Y型高精度LED芯片計數儀 >
- 萬深CountS2型在線自動數板儀/薄板計數儀/鋼板計數儀 >
- 萬深CountS2型在線自動數板儀薄板鋼板計數儀PCB板計數儀 >
- 萬深CountS1型自動數板儀薄板計數儀鋼板計數器(Automatic sheet counter) >
- 萬深LC-D2型雙排線束顏色順序檢測儀 >
- 萬深LC-D1型超細線束顏色順序檢測儀 >
- 萬深GMS服裝尺寸自動測量系統 >
- SC-B1型微小浮游動物自動計數儀(掃描款) >
- SC-B2型多功能魚卵貝苗自動計數儀 >
- SC-B型魚蝦苗自動測量分析儀 >
- 萬深SC-C型紙面蠶種自動計數儀 >

